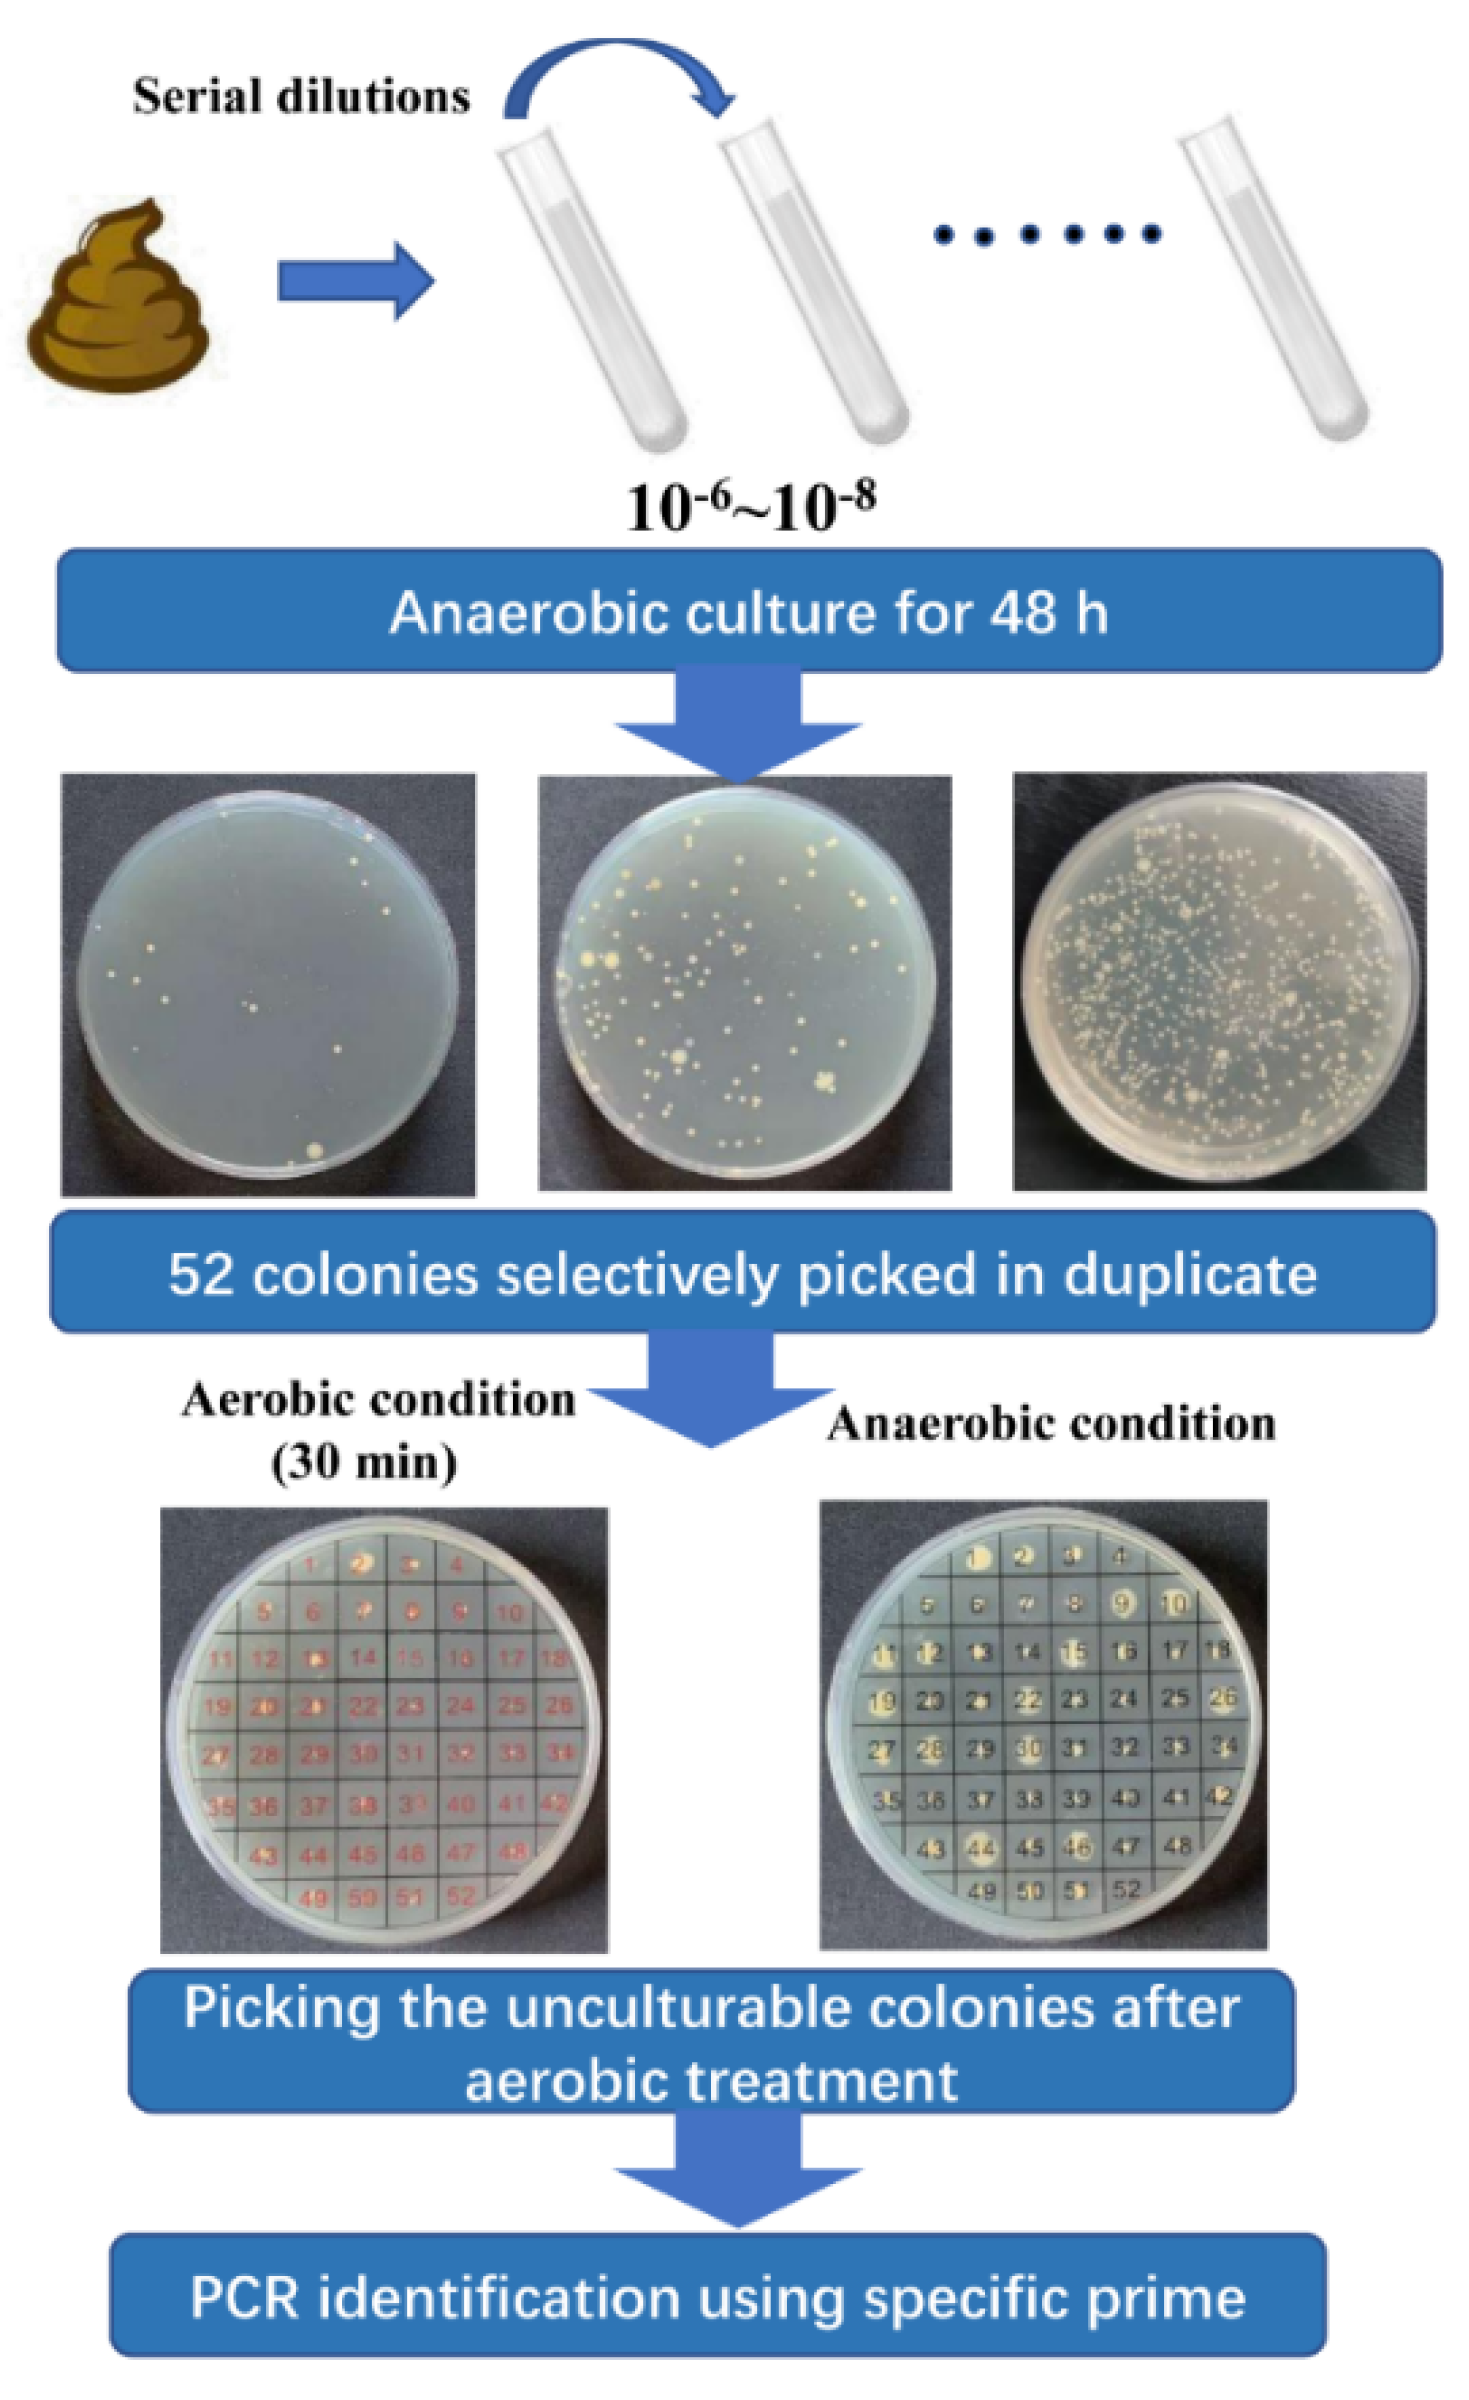
Microorganisms 10 00297 g001

Biodiversity and Physiological Characteristics of Novel Faecalibacterium prausnitzii Strains Isolated from Human Feces
Abstract
:1. Introduction
2. Materials and Methods
2.1. Bacterial Strains and Growth Conditions
2.2. Sample Collection and Isolation of F. prausnitzii Strains
2.3. Polygenetic Analysis
2.4. Scanning Electron Microscopy (SEM)
2.5. Growth Performance
2.6. Resistance to pH and Bile Salts
2.7. SCFAs Analysis
2.8. Determination of Antibiotics Resistance
2.9. Determination of Carbohydrate Utilization
2.10. Statistical Analysis
3. Results
3.1. Isolation and Identification of F. prausnitzii Strains
3.2. Phylogenetic Diversity of Faecalibacterium prausnitzii Strains
3.3. Growth Performance of F. prausnitzii Isolates
3.4. SCFAs Analysis
3.5. Resistance to Antibiotics
3.6. Carbohydrate Utilization
4. Discussion
Supplementary Materials
Author Contributions
Funding
Institutional Review Board Statement
Informed Consent Statement
Data Availability Statement
Acknowledgments
Conflicts of Interest
References
- Chang, P.V.; Hao, L.; Offermanns, S.; Medzhitov, R. The microbial metabolite butyrate regulates intestinal macrophage function via histone deacetylase inhibition. Proc. Natl. Acad. Sci. USA 2014, 111, 2247–2252. [Google Scholar] [CrossRef] [Green Version]
- Harusato, A.; Chassaing, B. Insights on the impact of diet—Mediated microbiota alterations on immunity and diseases. Am. J. Transplant. 2018, 18, 550–555. [Google Scholar] [CrossRef]
- Zou, Y.; Lin, X.; Xue, W.; Tuo, L.; Chen, M.-S.; Chen, X.-H.; Sun, C.-h.; Li, F.; Liu, S.-W.; Dai, Y.; et al. Characterization and description of Faecalibacterium butyricigenerans sp. nov. and F. longum sp. nov., isolated from human faeces. Sci. Rep. 2021, 11, 11340. [Google Scholar] [CrossRef]
- Schoch, C.L.; Ciufo, S.; Domrachev, M.; Hotton, C.L.; Kannan, S.; Khovanskaya, R.; Leipe, D.; McVeigh, R.; O’Neill, K.; Robbertse, B.; et al. NCBI Taxonomy: A comprehensive update on curation, resources and tools. Database 2020, 2020, baaa062. [Google Scholar] [CrossRef]
- Fitzgerald, C.B.; Shkoporov, A.N.; Sutton, T.D.S.; Chaplin, A.V.; Velayudhan, V.; Ross, R.P.; Hill, C. Comparative analysis of Faecalibacterium prausnitzii genomes shows a high level of genome plasticity and warrants separation into new species-level taxa. BMC Genom. 2018, 19, 1–20. [Google Scholar] [CrossRef] [Green Version]
- Lopez-Siles, M.; Duncan, S.H.; Garcia-Gil, L.J.; Martinez-Medina, M. Faecalibacterium prausnitzii: From microbiology to diagnostics and prognostics. ISME J. 2017, 11, 841–852. [Google Scholar] [CrossRef]
- Machiels, K.; Joossens, M.; Sabino, J.; De Preter, V.; Arijs, I.; Eeckhaut, V.; Ballet, V.; Claes, K.; Van Immerseel, F.; Verbeke, K. A decrease of the butyrate-producing species Roseburia hominis and Faecalibacterium prausnitzii defines dysbiosis in patients with ulcerative colitis. Gut 2014, 63, 1275–1283. [Google Scholar] [CrossRef]
- Cao, Y.; Shen, J.; Ran, Z.H. Association between Faecalibacterium prausnitzii reduction and inflammatory bowel disease: A meta-analysis and systematic review of the literature. Gastroent. Res. Pract. 2014, 2014, 872725. [Google Scholar] [CrossRef] [Green Version]
- Sokol, H.; Pigneur, B.; Watterlot, L.; Lakhdari, O.; Bermudez-Humaran, L.G.; Gratadoux, J.J.; Blugeon, S.; Bridonneau, C.; Furet, J.P.; Corthier, G.; et al. Faecalibacterium prausnitzii is an anti-inflammatory commensal bacterium identified by gut microbiota analysis of Crohn disease patients. Proc. Natl. Acad. Sci. USA 2008, 105, 16731–16736. [Google Scholar] [CrossRef] [Green Version]
- Miquel, S.; Martin, R.; Bridonneau, C.; Robert, V.; Sokol, H.; Bermudez-Humaran, L.G.; Thomas, M.; Langella, P. Ecology and metabolism of the beneficial intestinal commensal bacterium Faecalibacterium prausnitzii. Gut Microbes 2014, 5, 146–151. [Google Scholar] [CrossRef] [Green Version]
- Rossi, O.; Khan, M.T.; Schwarzer, M.; Hudcovic, T.; Srutkova, D.; Duncan, S.H.; Stolte, E.H.; Kozakova, H.; Flint, H.J.; Samsom, J.N.; et al. Faecalibacterium prausnitzii strain HTF-F and its extracellular polymeric matrix attenuate clinical parameters in DSS-Induced colitis. PLoS ONE 2015, 10, e0123013. [Google Scholar] [CrossRef] [Green Version]
- Miquel, S.; Martin, R.; Lashermes, A.; Gillet, M.; Meleine, M.; Gelot, A.; Eschalier, A.; Ardid, D.; Bermudez-Humaran, L.G.; Sokol, H.; et al. Anti-nociceptive effect of Faecalibacterium prausnitzii in non-inflammatory IBS-like models. Sci. Rep. 2016, 6, 19399. [Google Scholar] [CrossRef] [Green Version]
- Kawade, Y.; Sakai, M.; Okamori, M.; Morita, M.; Mizushima, K.; Ueda, T.; Takagi, T.; Naito, Y.; Itoh, Y.; Shimada, T. Administration of live, but not inactivated, Faecalibacterium prausnitzii has a preventive effect on dextran sodium sulfate-induced colitis in mice. Mol. Med. Rep. 2019, 20, 25–32. [Google Scholar] [CrossRef]
- Ganesan, K.; Chung, S.K.; Vanamala, J.; Xu, B. Causal relationship between diet-Induced gut microbiota changes and diabetes: A novel strategy to transplant Faecalibacterium prausnitzii in preventing diabetes. Int. J. Mol. Sci. 2018, 19, 3720. [Google Scholar] [CrossRef] [Green Version]
- Munukka, E.; Rintala, A.; Toivonen, R.; Nylund, M.; Yang, B.; Takanen, A.; Hanninen, A.; Vuopio, J.; Huovinen, P.; Jalkanen, S.; et al. Faecalibacterium prausnitzii treatment improves hepatic health and reduces adipose tissue inflammation in high-fat fed mice. ISME J. 2017, 11, 1667–1679. [Google Scholar] [CrossRef] [Green Version]
- Miquel, S.; Martin, R.; Rossi, O.; Bermudez-Humaran, L.G.; Chatel, J.M.; Sokol, H.; Thomas, M.; Wells, J.M.; Langella, P. Faecalibacterium prausnitzii and human intestinal health. Curr. Opin. Microbiol. 2013, 16, 255–261. [Google Scholar] [CrossRef]
- Duncan, S.H.; Hold, G.L.; Harmsen, H.J.M.; Stewart, C.S.; Flint, H.J. Growth requirements and fermentation products of Fusobacterium prausnitzii, and a proposal to reclassify it as Faecalibacterium prausnitzii gen. nov., comb. nov. Int. J. Syst. Evol. Microbiol. 2002, 52, 2141–2146. [Google Scholar]
- Martin, R.; Miquel, S.; Benevides, L.; Bridonneau, C.; Robert, V.; Hudault, S.; Chain, F.; Berteau, O.; Azevedo, V.; Chatel, J.M.; et al. Functional characterization of novel Faecalibacterium prausnitzii strains isolated from healthy volunteers: A step forward in the use of F. prausnitzii as a next-generation probiotic. Front. Microbiol. 2017, 8, 1226. [Google Scholar] [CrossRef]
- De Filippis, F.; Pasolli, E.; Ercolini, D. Newly explored Faecalibacterium diversity Is connected to age, lifestyle, geography, and disease. Curr. Biol. 2020, 30, 4932–4943. [Google Scholar] [CrossRef]
- Barcenilla, A.; Pryde, S.E.; Martin, J.C.; Duncan, S.H.; Stewart, C.S.; Henderson, C.; Flint, H.J. Phylogenetic relationships of butyrate-producing bacteria from the human gut. Appl. Environ. Microbiol. 2000, 66, 1654–1661. [Google Scholar] [CrossRef] [Green Version]
- Packeiser, H.; Lim, C.; Balagurunathan, B.; Wu, J.; Zhao, H. An extremely simple and effective colony PCR procedure for bacteria, yeasts, and microalgae. Appl. Biochem. Biotechnol. 2013, 169, 695–700. [Google Scholar] [CrossRef]
- Hedges, A.J. Estimating the precision of serial dilutions and viable bacterial counts. Int. J. Food Microbiol. 2002, 76, 207–214. [Google Scholar] [CrossRef]
- Mao, B.; Li, D.; Ai, C.; Zhao, J.; Zhang, H.; Chen, W. Lactulose differently modulates the composition of luminal and mucosal microbiota in C57BL/6J mice. J. Agric. Food Chem. 2016, 64, 6240–6247. [Google Scholar] [CrossRef]
- International Organization for Standardization (ISO). Milk and Milk Products: Determination of the Minimal Inhibitory Concentration (MIC) of Antibiotics Applicable to Bibidobacteria and Non-Enterococcal Lactic Acid Bacteria (LAB); ISO 10932:2010 (IDF 223:2010); ISO: Geneva, Switzerland, 2010; Available online: https://www.iso.org/standard/46434.html (accessed on 20 July 2020).
- Additives, E.P.o.; Feed, P.o.S.u.i.A.; Rychen, G.; Aquilina, G.; Azimonti, G.; Bampidis, V.; Bastos, M.d.L.; Bories, G.; Chesson, A.; Cocconcelli, P.S.; et al. Guidance on the characterisation of microorganisms used as feed additives or as production organisms. EFSA J. 2018, 16, e05206. [Google Scholar]
- Hornef, M.W.; Pabst, O. Real friends: Faecalibacterium prausnitzii supports mucosal immune homeostasis. Gut 2016, 65, 365–367. [Google Scholar] [CrossRef]
- He, X.; Zhao, S.; Li, Y.; Chen, T. Faecalibacterium prausnitzii: A next-generation probiotic in gut disease improvement. Can. J. Infect. Dis. Med. 2021, 2021, 6666114. [Google Scholar] [CrossRef]
- Quevrain, E.; Maubert, M.A.; Michon, C.; Chain, F.; Marquant, R.; Tailhades, J.; Miquel, S.; Carlier, L.; Bermudez-Humaran, L.G.; Pigneur, B.; et al. Identification of an anti-inflammatory protein from Faecalibacterium prausnitzii, a commensal bacterium deficient in Crohn’s disease. Gut 2016, 65, 415–425. [Google Scholar] [CrossRef] [Green Version]
- Tian, Y.; Wang, K.M.; Ji, G.Z. Faecalibacterium prausnitzii prevents tumorigenesis in a model of colitis-associated colorectal cancer. Gastroenterology 2017, 152, S354–S355. [Google Scholar] [CrossRef]
- Foditsch, C.; Santos, T.M.; Teixeira, A.G.; Pereira, R.V.; Dias, J.M.; Gaeta, N.; Bicalho, R.C. Isolation and characterization of Faecalibacterium prausnitzii from calves and piglets. PLoS ONE 2014, 9, e116465. [Google Scholar] [CrossRef] [Green Version]
- Lopez-Siles, M.; Khan, T.M.; Duncan, S.H.; Harmsen, H.J.M.; Garcia-Gil, L.J.; Flint, H.J. Cultured representatives of two major phylogroups of human colonic Faecalibacterium prausnitzii can utilize pectin, uronic acids, and host-derived substrates for growth. Appl. Environ. Microbiol. 2012, 78, 420–428. [Google Scholar] [CrossRef] [Green Version]
- Benevides, L.; Burman, S.; Martin, R.; Robert, V.; Thomas, M.; Miquel, S.; Chain, F.; Sokol, H.; Bermudez-Humaran, L.G.; Morrison, M.; et al. New insights into the diversity of the genus Faecalibacterium. Front. Microbiol. 2017, 8, 1790. [Google Scholar] [CrossRef] [PubMed]
- Smith, J.L. The role of gastric acid in preventing foodborne disease and how bacteria overcome acid conditions. J. Food Prot. 2003, 66, 1292–1303. [Google Scholar] [CrossRef] [PubMed]
- Koziolek, M.; Grimm, M.; Becker, D.; Iordanov, V.; Zou, H.; Shimizu, J.; Wanke, C.; Garbacz, G.; Weitschies, W. Investigation of pH and temperature profiles in the GI tract of fasted human subjects using the Intellicap®system. J. Pharm. Sci. 2015, 104, 2855–2863. [Google Scholar] [CrossRef] [PubMed]
- Jia, W.; Xie, G.; Jia, W. Bile acid-microbiota crosstalk in gastrointestinal inflammation and carcinogenesis. Nat. Rev. Gastroenterol. Hepatol. 2018, 15, 111–128. [Google Scholar] [CrossRef] [Green Version]
- Jiao, N.; Baker, S.S.; Chapa-Rodriguez, A.; Liu, W.; Nugent, C.A.; Tsompana, M.; Mastrandrea, L.; Buck, M.J.; Baker, R.D.; Genco, R.J. Suppressed hepatic bile acid signalling despite elevated production of primary and secondary bile acids in NAFLD. Gut 2018, 67, 1881–1891. [Google Scholar] [CrossRef]
- den Besten, G.; van Eunen, K.; Groen, A.K.; Venema, K.; Reijngoud, D.J.; Bakker, B.M. The role of short-chain fatty acids in the interplay between diet, gut microbiota, and host energy metabolism. J. Lipid Res. 2013, 54, 2325–2340. [Google Scholar] [CrossRef] [Green Version]
- Louis, P.; Flint, H.J. Formation of propionate and butyrate by the human colonic microbiota. Environ. Microbiol. 2017, 19, 29–41. [Google Scholar] [CrossRef] [Green Version]
- Canfora, E.E.; Jocken, J.W.; Blaak, E.E. Short-chain fatty acids in control of body weight and insulin sensitivity. Nat. Rev. Endocrinol. 2015, 11, 577–591. [Google Scholar] [CrossRef]
- Hazards, E.P.o.B. Scientific Opinion on the maintenance of the list of QPS biological agents intentionally added to food and feed (2013 update). EFSA J. 2013, 11, 3449. [Google Scholar]
- Hill, C.; Guarner, F.; Reid, G.; Gibson, G.R.; Merenstein, D.J.; Pot, B.; Morelli, L.; Canani, R.B.; Flint, H.J.; Salminen, S.; et al. The International Scientific Association for Probiotics and Prebiotics consensus statement on the scope and appropriate use of the term probiotic. Nat. Rev. Gastro. Hepat. 2014, 11, 506–514. [Google Scholar] [CrossRef] [Green Version]
- Schjørring, S.; Krogfelt, K.A. Assessment of bacterial antibiotic resistance transfer in the gut. Int. J. Microbiol. 2011, 2011, 312956. [Google Scholar] [CrossRef] [Green Version]
- Matsuki, T.; Yahagi, K.; Mori, H.; Matsumoto, H.; Hara, T.; Tajima, S.; Ogawa, E.; Kodama, H.; Yamamoto, K.; Yamada, T. A key genetic factor for fucosyllactose utilization affects infant gut microbiota development. Nat. Commun. 2016, 7, 11939. [Google Scholar] [CrossRef] [PubMed]
- Food & Drug Administration. Guidance for Industry: The Declaration of Certain Isolated or Synthetic Non-Digestible Carbohydrates as Dietary Fiber on Nutrition and Supplement Facts Labels. 2018. Available online: https://www.fda.gov/regulatory-information/search-fda-guidance-documents/guidance-industry-declaration-certain-isolated-or-synthetic-non-digestible-carbohydrates-dietary (accessed on 11 August 2021).
- Gupta, N.; Jangid, A.K.; Pooja, D.; Kulhari, H. Inulin: A novel and stretchy polysaccharide tool for biomedical and nutritional applications. Int.J. Biol. Macromol. 2019, 132, 852–863. [Google Scholar] [CrossRef]
- Vandeputte, D.; Falony, G.; Vieira-Silva, S.; Wang, J.; Sailer, M.; Theis, S.; Verbeke, K.; Raes, J. Prebiotic inulin-type fructans induce specific changes in the human gut microbiota. Gut 2017, 66, 1968–1974. [Google Scholar] [CrossRef] [PubMed]
- Chung, M.; Munro, J.B.; Tettelin, H.; Hotopp, J.C.D.; Dorrestein, P.C. Using core genome alignments to assign bacterial species. mSystems 2018, 3, e00236-18. [Google Scholar] [CrossRef] [PubMed] [Green Version]

| Subject | Sex | Age (Years) | Isolation Source | %EOS | Identified F. prausnitzii Strains | Accession Number |
|---|---|---|---|---|---|---|
| A | M | 28 | Human feces | 42.3 | FJNHS1Y51 | OL587609 |
| B | M | 25 | Human feces | 53.5 | FJNJZ1Y10 | OL587617 |
| FJNJZ1Y25 | OL587618 | |||||
| FJNJZ1Y27 | OL587619 | |||||
| FJNJZ1Y40 | OL587620 | |||||
| C | F | 56 | Human feces | 34.6 | FJNPY1Y39 | OL587608 |
| D | F | 25 | Human feces | 38.5 | FJNQL1Y13 | OL587633 |
| FJNQL1Y33 | OL587621 | |||||
| E | M | 28 | Human feces | 57.7 | FJNLA1Y02 | OL587622 |
| FJNLA1Y08 | OL587623 | |||||
| FJNLA1Y11 | OL587624 | |||||
| FJNLA1Y27 | OL587625 | |||||
| FJNLA1Y29 | OL587626 | |||||
| FJNLA1Y38 | OL587627 | |||||
| FJNLB1Y08 | OL587628 | |||||
| FJNLB1Y11 | OL587629 | |||||
| FJNLB1Y16 | OL587630 | |||||
| FJNLB1Y25 | OL587631 | |||||
| FJNLB1Y49 | OL587632 | |||||
| F | F | 28 | Human feces | 38.5 | FJNSM1Y10 | OL587615 |
| FJNSM1Y12 | OL587616 | |||||
| G | M | 32 | Human feces | 40.4 | FJNHW1Y09 | OL587610 |
| FJNHW1Y29 | OL587611 | |||||
| H | F | 30 | Human feces | 36.5 | FJNXY1Y35 | OL587612 |
| I | M | 36 | Human feces | 51.9 | FJNZF1Y21 | OL587613 |
| FJNZF1Y25 | OL587614 |
| Antibiotic | Distribution of Isolates | Percentage of Resistant Isolates (%) | MIC50 | MIC90 | |||||||||||||
|---|---|---|---|---|---|---|---|---|---|---|---|---|---|---|---|---|---|
| ~0.03 | ~0.25 | 0.5 | 1 | 2 | 4 | 8 | 16 | 32 | 64 | 128 | 256 | 512 | 1024~ | ||||
| Trimethoprim | - | 1 | - | 2 | - | - | - | 1 | 3 | 20 | - | - | - | - | ND | 64 | 64 |
| Ciprofloxacin | - | 1 | 2 | 1 | 4 | 13 | 4 | 2 | - | - | - | - | - | - | ND | 4 | 8 |
| Ampicillin | - | 2 | 12 | 7 | 2 | 3 | - | 1 | - | - | - | - | - | - | 22.2 | 0.5 | 4 |
| Vancomycin | - | 16 | 7 | 2 | 2 | - | - | - | -- | - | - | - | - | 0 | 0.25 | 1 | |
| Kanamycin | - | - | - | - | - | - | 1 | 3 | 9 | 5 | 2 | - | 3 | 4 | 85.2 | 64 | 1024 |
| Gentamicin | - | - | - | - | 1 | 4 | 2 | 10 | 4 | 1 | 1 | 4 | - | - | 81.5 | 16 | 256 |
| Streptomycin | - | - | 2 | 1 | 4 | 7 | 11 | 1 | - | - | 1 | - | - | - | 7.4 | 4 | 8 |
| Tetracycline | - | 18 | 4 | 1 | - | 1 | - | - | 3 | - | - | - | - | - | 14.8 | 0.25 | 4 |
| Clindamycin | 10 | 5 | 3 | 1 | 1 | 5 | 2 | - | - | - | - | - | 7.4 | 0.25 | 4 | ||
| Erythromycin | - | 5 | 3 | 8 | 3 | - | 8 | - | - | - | - | - | - | - | 40.7 | 1 | 8 |
| Chloramphenicol | - | 5 | 5 | 4 | 6 | 1 | 3 | 3 | - | - | - | - | - | - | 22.2 | 1 | 8 |
| Neomycin | - | - | - | - | - | 3 | 11 | 9 | 1 | - | 3 | - | - | ND | 8 | 32 | |
| Strains | Glu | Mal | Fru | Ara | Cel | Raf | Rha | Rib | Suc | Xyl | Man | Mai | Gal | Lac | Tre | Sor | SS | In | 2F |
|---|---|---|---|---|---|---|---|---|---|---|---|---|---|---|---|---|---|---|---|
| A2-165 | + | + | + | - | + | - | - | - | - | - | - | - | + | + | - | - | + | + | - |
| FJNHS1Y51 | + | + | + | - | + | - | - | - | - | - | w | - | w | w | w | - | - | + | - |
| FJNJZ1Y10 | + | + | + | - | + | - | w | - | w | - | + | - | + | w | - | - | - | + | - |
| FJNJZ1Y25 | + | + | w | - | + | - | w | - | w | - | + | - | + | + | - | - | - | + | - |
| FJNJZ1Y27 | + | + | + | - | + | - | w | - | w | - | w | - | + | w | + | - | - | w | - |
| FJNJZ1Y40 | + | w | + | - | + | - | w | - | + | - | w | - | w | w | w | - | + | w | - |
| FJNPY1Y39 | + | - | + | - | - | - | w | - | - | - | - | - | - | - | - | - | - | - | - |
| FJNQL1Y13 | + | - | + | - | - | - | - | - | w | - | - | - | - | - | - | - | - | w | - |
| FJNQL1Y33 | + | w | w | - | w | - | - | - | + | - | - | - | - | - | - | - | - | - | - |
| FJNLA1Y02 | + | w | + | - | + | - | - | - | w | - | w | - | w | w | - | - | - | + | - |
| FJNLA1Y08 | + | - | + | - | - | - | - | - | - | - | w | - | - | - | - | - | - | + | - |
| FJNLA1Y11 | + | - | + | - | - | - | - | - | - | - | w | - | - | - | - | - | - | + | - |
| FJNLA1Y27 | + | + | + | w | + | - | - | - | + | - | + | - | - | - | + | - | - | + | - |
| FJNLA1Y29 | + | + | + | + | + | - | - | - | + | - | + | - | + | + | + | - | - | + | - |
| FJNLA1Y38 | + | + | + | - | + | - | - | - | w | - | w | - | w | w | + | - | - | + | - |
| FJNLB1Y08 | + | + | + | - | + | - | - | - | - | - | w | - | + | - | - | - | - | w | - |
| FJNLB1Y11 | + | w | + | - | + | - | - | - | - | - | w | - | w | w | - | - | - | w | - |
| FJNLB1Y16 | + | + | + | - | w | - | - | - | + | - | + | - | + | + | - | - | - | + | - |
| FJNLB1Y25 | + | + | w | - | + | + | + | + | + | - | w | - | + | + | + | - | w | + | - |
| FJNLB1Y49 | + | + | + | - | + | - | - | - | - | - | w | - | + | + | w | - | w | w | - |
| FJNSM1Y10 | + | + | + | - | + | - | w | - | - | - | w | - | w | w | - | - | - | w | - |
| FJNSM1Y12 | + | + | + | - | + | - | + | - | w | - | + | - | + | w | - | - | - | + | - |
| FJNHW1Y09 | + | + | w | - | + | - | - | - | w | - | + | - | w | w | + | - | - | + | - |
| FJNHW1Y29 | + | + | w | - | w | - | - | - | w | - | w | - | w | w | w | - | w | + | - |
| FJNXY1Y35 | + | + | + | - | + | - | - | - | - | - | w | - | + | - | - | - | - | w | - |
| FJNZF1Y21 | + | + | w | - | w | - | + | - | w | - | w | w | w | w | + | - | w | w | - |
| FJNZF1Y25 | + | + | w | - | w | - | + | - | w | - | w | w | w | w | + | - | w | + | - |
Publisher’s Note: MDPI stays neutral with regard to jurisdictional claims in published maps and institutional affiliations. |
© 2022 by the authors. Licensee MDPI, Basel, Switzerland. This article is an open access article distributed under the terms and conditions of the Creative Commons Attribution (CC BY) license (https://creativecommons.org/licenses/by/4.0/).
Share and Cite
Hu, W.; Gao, W.; Liu, Z.; Fang, Z.; Zhao, J.; Zhang, H.; Lu, W.; Chen, W. Biodiversity and Physiological Characteristics of Novel Faecalibacterium prausnitzii Strains Isolated from Human Feces. Microorganisms 2022, 10, 297. https://doi.org/10.3390/microorganisms10020297
Hu W, Gao W, Liu Z, Fang Z, Zhao J, Zhang H, Lu W, Chen W. Biodiversity and Physiological Characteristics of Novel Faecalibacterium prausnitzii Strains Isolated from Human Feces. Microorganisms. 2022; 10(2):297. https://doi.org/10.3390/microorganisms10020297
Chicago/Turabian StyleHu, Wenbing, Wenyu Gao, Zongmin Liu, Zhifeng Fang, Jianxin Zhao, Hao Zhang, Wenwei Lu, and Wei Chen. 2022. "Biodiversity and Physiological Characteristics of Novel Faecalibacterium prausnitzii Strains Isolated from Human Feces" Microorganisms 10, no. 2: 297. https://doi.org/10.3390/microorganisms10020297
APA StyleHu, W., Gao, W., Liu, Z., Fang, Z., Zhao, J., Zhang, H., Lu, W., & Chen, W. (2022). Biodiversity and Physiological Characteristics of Novel Faecalibacterium prausnitzii Strains Isolated from Human Feces. Microorganisms, 10(2), 297. https://doi.org/10.3390/microorganisms10020297

